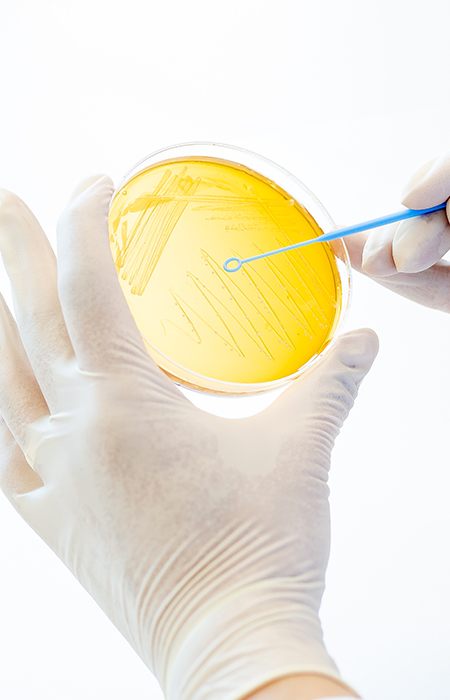

About Us
AceBiome
AceBiome, a dietary supplements company supplying probiotics products based on microbiome research,spun out of Bioneer Corporation in 2017 and was founded as a subsidiary of Bioneer.
Lactobacillus gasseri BNR17™, researched and developed for about twenty years by the researchers of Bioneer and AceBiome, is the first probiotic strain approved by MFDS (Korea FDA) as a functional ingredient to help reduce body fat, and is currently a globally patented probiotic for weight control and diabetes. Centered around BNR17™ probiotic products that ameliorate overweight and obesity, AceBiome is a fast-growing, global company that seeks to improve human health and quality of life.



AceBiome R&D Center
AceBiome’s R&D Team is pioneering to discover new functional probiotics through microbiome research which would be beneficial for human health. The team is tirelessly striving to develop probiotics to help create a healthy intestinal ecosystem and optimal microbiome.

CEO Message
"At AceBiome, we strive for your health and happiness every day."

We research and develop premium health supplements to enhance your quality of life and overall wellbeing. Through rigorous scientific research and continuous innovation, we pioneer advanced health solutions, including probiotics, and bring them to life as the best possible products that safeguard your health.
As we embrace the longevity revolution, our bodies undergo continuous changes, as do our health requirements. To address these evolving needs, we create tailored solutions optimized for specific demographics-from children to adults and seniors-accounting for age, gender, and functional requirements. Our mission is to support each individual on their unique journey toward optimal health.
We strive to contribute to the health and happiness of communities worldwide by delivering superior, science-backed nutritional products.
At AceBiome, we embrace new challenges daily to secure a healthier future for all. We sincerely value your continued trust and support.
CEO Myeong Hee Kim
History

2024
Nov Surpassed 14 Million Units Sold of BNRThin Brand
(Jan. 2020-Oct. 2024)
Total Sales of BNRThin Brand Reached 530 Million USD
(Nov.2018-Oct. 2024)
Nov Won the “2024 Venture Startup Achievement Award”,
hosted by the Minister of SMEs and Startups Award
Sep Etnacare released
Sep Won the “Nutralngredients-Asia Awards
– Sports Nutrition Product of the Year 2024″ (AnaPactin)
Sep Won the “Brand of the Year Award 2024” (BNRThin, BNRQueen)
Aug AceBiome Multivitamin released
Jul BNRThin entered Korean Air In-Flight Duty-Free
Apr Won the “2024 Medical Healthcare Award – Probiotics”
Jan Won the “2024 Korea’s First Brand Award(BNRThin, BNR Queen)”

2023
Total Sales of BNRThin Brand Reached 380 Million USD Nov
(Nov. 2018 – Nov. 2023)
Surpassed 10 Million Units Sold of BNRThin Brand
(Jan. 2020-Nov. 2023)
AnaParactin Balm released Sep
Won the “Brand of the Year Award 2023 (BNRThin, BNRQueen)” Sep
AB-Immune released Jun
Won the “Brand Customer Loyalty Awards 2023” (BNRThin, BNRQueen) May
AnaParactin released Apr
Won the “2022 Korea Best Management Award” Mar
Won the “2023 Korea’s First Brand Award (BNRThin)” Jan
2022
Sep Won the “Brand of the Year Award 2022 (BNRThin)”
Apr Won the “2022 IR52 Jang Young-Sil Award”,
hosted by the Ministry of Science and ICT
Mar Won the “2022 Korea Best Management Award”

2021
BNRThin Protein released Sep
Won the “Award of Ministry of Food and Drug Safety” Aug
Won the “2021 Medical Healthcare Award – Probiotics” Mar
Won the “2021 Korea’s Best Management Award” Mar
Selected as a “Women-Friendly Product in the Innovation Brand” Feb
(BNRThin)
Won the “Sustainable Management Grand Prize” Feb

2020
Sep ‘BNRThin(비에날씬), BNRThin Pro’ incorporating BNR17® won the award of Product of the Year in Probiotic from Nutralngredients- Asia Awards 2020
Aug Won the “Award of Minister of SMEs and Startups”
Jul BNR Liver Care released
Mar Won the “2020 The Korea’s Influential CEO Award”
Feb BNR Kids released
Feb Headquarter of AceBiome moved to World Trade Center Seoul
(Trade Tower)

2019
Venture Enterprise Certification Dec
Won “The Korean Influential Brand Awards” Nov
BNR17® registered with ANVISA, Brazil Jul
BNR17® presented at Hi & Fi Asia China (Shanghai) Jun
Marketing permission of BNRThin given by Vietnam Food Administration. Jun
BNR17® showcase and presentation at Vitafoods Europe (Geneva) May
BNR17® showcase at BIO KOREA (COEX, Seoul) Apr
BNR17® showcase at Natural Products Expo in Anaheim, USA Mar
Won the “Award of Ministry of Food and Drug Safety” Feb

2018
Dec AceBiome R&D Center established
Nov BNRThin, BNR17® weight management probiotic product launched on
BNRmall
Jul BNR17® won Ingredient of the Year: Weight Management category of the
Nutralngredients-USA Awards 2018
May Supply Agreement of BNR17® products with Cristalia, Brazil
Apr BNR17® licensing agreement with UAS Labs

